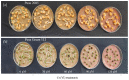

Effect of chromium (VI) toxicity on morpho-physiological characteristics, yield, and yield components of two chickpea (Cicer arietinum L.) varieties
- PMID: 33270694
- PMCID: PMC7714171
- DOI: 10.1371/journal.pone.0243032
Effect of chromium (VI) toxicity on morpho-physiological characteristics, yield, and yield components of two chickpea (Cicer arietinum L.) varieties
Abstract
The ever-increasing industrial activities over the decades have generated high toxic metal such as chromium (Cr) that hampers the crop productivity. This study evaluated the effect of Cr on two chickpea (Cicer arietinum L.) varieties, Pusa 2085 and Pusa Green 112, in hydroponic and pot-grown conditions. First, growth parameters (seed germination, seedling growth, and biomass production) and physio-biochemical parameters (oxidative stress and the content of antioxidants and proline) were measured to evaluate the performance of both varieties grown hydroponically for 21 days at concentrations of 0, 30, 60, 90 and 120 μM Cr in the form of potassium dichromate (K2Cr2O7). In both varieties, significantly deleterious effects on germination and seedling growth parameters were observed at 90 and 120 μM, while growth was stimulated at 30 μM Cr. Significant increases in malondialdehyde and hydrogen peroxide content and electrolyte leakage demonstrated enhanced oxidative injury to seedlings caused by higher concentrations of Cr. Further, increasing concentrations of Cr positively correlated with increased proline content, superoxide dismutase activity, and peroxide content in leaves. There was also an increase in peroxisomal ascorbate peroxidase and catalase in the leaves of both varieties at lower Cr concentrations, whereas a steep decline was recorded at higher Cr concentrations. In the pot experiments conducted over two consecutive years, growth, yield, yield attributes, grain protein, and Cr uptake and accumulation were measured at different Cr concentrations. Pusa Green 112 showed a significant reduction in plant growth, chlorophyll content, grain protein, pod number, and grain yield per plant when compared with Pusa 2085. Overall, our results indicate that Pusa 2085 has a higher Cr tolerance than Pusa Green 112. Therefore, Pusa 2085 could be used to further elucidate the mechanisms of Cr tolerance in plants and in breeding programmes to produce Cr-resistant varieties.
Conflict of interest statement
The authors have declared that no competing interests exist.
Figures

References
-
- Diwan H, Khan I, Ahmad A, Iqbal M. Induction of phytochelatins and antioxidant defence system in Brassica juncea and Vigna radiata in response to chromium treatments. Plant Growth Regul. 2010; 61(1):97–107.10.1007/s10725-010-9454-0 - DOI
-
- Nagajyoti PC, Lee KD, Sreekanth TV. Heavy metals, occurrence and toxicity for plants: a review. Environ Chem Lett. 2010; 8(3):199–216.10.1007/s10311-010-0297-8 - DOI
-
- Ali Z, Malik RN, Shinwari ZK, Qadir A. Enrichment, risk assessment, and statistical apportionment of heavy metals in tannery-affected areas. Int J Environ Sci Tech. 2015; 12(2):537–550.10.1007/s13762-013-0428-4 - DOI
MeSH terms
Substances
LinkOut - more resources
Full Text Sources

